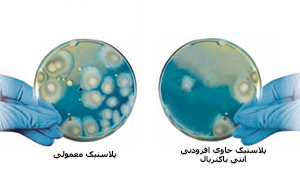

امروزه، استفاده از ترولی نظافتی بعنوان ابزاری ساده و در عین حال کارآمد در محیطهای گوناگون رو به افزایش میباشد. با استفاده از ترولی کاربر در هر لحظه به کلیه ابزار،تجهیزات و مواد نظافت مورد نیاز دسترسی داشته، قادر به جمع آوری، تفکیک و حمل زباله بوده و می تواند عملیات مختلف شستشو و نظافت را همزمان مدیریت نماید. نیاز مبرم محیط هایی نظیر بیمارستانها، درمانگاه ها و سرای سالمندان به نظافت و شستشوی پیوسته و اهمیت سرعت انجام عملیات نظافتی در این محیط ها، لزوم کاربرد ترولی در آنها را مشخص می نماید. ترولی های مورد استفاده در محیط های نیازمند سطح بالای بهداشت، که عموما با نام ترولی بیمارستانی شناخته می شوند، دارای ویژگی های خاصی میباشند که آنها را از انواع دیگر ترولی متمایز می نماید. در این مقاله ترولی بیمارستانی و ویژگی های آن مورد بررسی قرار گرفته است.
اهمیت انتخاب ترولی بیمارستانی مناسب
 انتشار انواع باکتریها در بیمارستانها، درمانگاهها، کلینیکها و مراکز درمانیT چالشی جدی و نگران کنندهبه حساب می آید. طبق بررسی های انجام شده هر ساله ، از هر ۱۰ میلیون بیمار، ۷۰۰ هزار نفر در طول دوران بستری شدن خود در بیمارستان، به عفونت باکتریایی مبتلا میشوند. یکی از دلایل اصلی انتشار عفونت در مراکز درمانی، سطح پایین بهداشت و نظافت در آنها میباشد. ترولی بیمارستانی بعنوان یکی از ابزارهای اصلی نظافت و شستشو در محیط های نیازمند سطح بالای بهداشت شناخته می شوند. ماهیت عملکرد ترولی بعنوان ابزاری برای حمل و جابجایی سایر تجهیزات نظافتی و زباله می تواند این ابزار را به عاملی برای انتقال و انتشار باکتری و میکروب در محیط تبدیل نماید. بنابراین طراحی و تولید یک ترولی بیمارستانی باید به گونه ای صورت پذیرد که خطر انتقال و انتشار باکتری و آلودگی توسط این ابزار را به حداقل کاهش دهد.
انتشار انواع باکتریها در بیمارستانها، درمانگاهها، کلینیکها و مراکز درمانیT چالشی جدی و نگران کنندهبه حساب می آید. طبق بررسی های انجام شده هر ساله ، از هر ۱۰ میلیون بیمار، ۷۰۰ هزار نفر در طول دوران بستری شدن خود در بیمارستان، به عفونت باکتریایی مبتلا میشوند. یکی از دلایل اصلی انتشار عفونت در مراکز درمانی، سطح پایین بهداشت و نظافت در آنها میباشد. ترولی بیمارستانی بعنوان یکی از ابزارهای اصلی نظافت و شستشو در محیط های نیازمند سطح بالای بهداشت شناخته می شوند. ماهیت عملکرد ترولی بعنوان ابزاری برای حمل و جابجایی سایر تجهیزات نظافتی و زباله می تواند این ابزار را به عاملی برای انتقال و انتشار باکتری و میکروب در محیط تبدیل نماید. بنابراین طراحی و تولید یک ترولی بیمارستانی باید به گونه ای صورت پذیرد که خطر انتقال و انتشار باکتری و آلودگی توسط این ابزار را به حداقل کاهش دهد.
ویژگی های ترولی بیمارستانی
همانگونه که ذکر گردید طراحی و تولید ترولی بیمارستانی باید به گونه ای صورت گیرد که خطر انتقال آلودگی توسط آن به حداقل کاهش یافته و دست یابی به سطح بالای بهداشت را هنگام کاربرد تأمین نماید. در نتیجه در تولید ترولی بیمارستانی ویژگیهای خاصی لحاظ می گردد تا سلامت و ایمنی بیماران، کارکنان و مراجعه کنندگان در محیط هایی همانند بیمارستان ها، سرای سالمندان و مهدکودک ها تضمین گردد. برخی از ویژگی های متمایز کننده ترولی بیمارستانی عبارتند از:
استفاده از مواد آنتی باکتریال
مهمترین مشخصه یک ترولی بیمارستانی استاندارد، استفاده از افزودنی های آنتی باکتریال در تولید این ترولی میباشد. این افزودنی ها به ماده اصلی تشکیل دهنده ترولی اضافه می شوند و در نتیجه وارد ماتریس پلی مری آن شده و در اثر شستشو یا عملیات نظافتی دیگر از ساختار ماده خارج نمی شوند. بنابراین تا زمانیکه ترولی بیمارستانی قابل استفاده میباشد، خاصیت آنتی باکتریال خود را حفظ مینماید. بهترین افزودنی های ضد باکتری، یون نقره و پریتیون روی می باشند. این افزودنی ها مضر نبوده و هنگام بازیافت خطری برای انسان یا محیط زیست ایجاد نمی کنند.
مهمترین مشخصه یک ترولی بیمارستانی استاندارد، استفاده از افزودنی های آنتی باکتریال در تولید این ترولی میباشد. این افزودنی ها به ماده اصلی تشکیل دهنده ترولی اضافه می شوند و در نتیجه وارد ماتریس پلی مری آن شده و در اثر شستشو یا عملیات نظافتی دیگر از ساختار ماده خارج نمی شوند. بنابراین تا زمانیکه ترولی بیمارستانی قابل استفاده میباشد، خاصیت آنتی باکتریال خود را حفظ مینماید. بهترین افزودنی های ضد باکتری، یون نقره و پریتیون روی می باشند. این افزودنی ها مضر نبوده و هنگام بازیافت خطری برای انسان یا محیط زیست ایجاد نمی کنند.
این افزودنی ها به دیواره سلولی میکرو ارگانها نفود کرده و مانع رشد و تکثیر آنها می شوند. شکل مقابل میزان حضور و رشد باکتری ها را بر روی یک سطح پلیمری حاوی افزودنی های آنتی باکتریال در مقایسه با سطح پلیمری معمولی نشان می دهد.
سهولت نظافت
وجود انواع آلودگی های خطرناک در مراکز درمانی نظیر بیمارستان ها، اهمیت شستشو و نظافت کامل و مداوم یک ترولی بیمارستانی را مشخص می نماید. در نتیجه ماده اصلی به کار رفته در تولید ترولی بیمارستانی باید کاملا قابل شستشو باشد. یکی از بهترین مواد مورد استفاده در تولید ترولی بیمارستانی پلی پروپیلن میباشد. این ماده کاملا قابل شستشو بوده و افزون بر آن قابل بازیافت و سازگار با محیط زیست می باشد.
علاوه بر نوع ماده به کار رفته در تولید، طراحی یک ترولی بیمارستانی نیز باید به گونه ای باشد که امکان نظافت و شستشوی راحت آن را فراهم نماید. انواع مدرن ترولی بیمارستانی به روش ماژولار طراحی می شوند. در این نوع طراحی، امکان جدا کردن و اتصال مجدد بخش های مختلف ترولی نظافت وجود دارد. در نتیجه می توان بخش های مختلف ترولی را از هم جدا کرده و بعد از تمیز نمودن، مجددا به هم متصل کرد.
محفظه های بسته و قفل دار

به منظور تأمین سطح بالای بهداشت و جلوگیری از آلوده شدن مواد و ابزار حمل شده توسط ترولی و همچنین جلوگیری از انتشار آلودگی مرتبط با زباله های جمع آوری و حمل شده توسط ترولی، بخش های مختلف ترولی باید به صورت کاملا بسته و مجهز به درپوش تولید شوند. لازم به ذکر است که در بخش هایی از محیط با ریسک کمتر آلودگی همانند بخش های اداری استفاده از درب و دیواره جانبی و درپوش برای ترولی ضروری نمی باشد. در هر صورت انتخاب یک ترولی ماژولار با قابلیت اضافه یا جدا کردن درب و درپوش به آن، انتخابی معقولانه و مقرون به صرفه خواهد بود که امکان کاربرد ترولی بیمارستانی را در بخش های مختلف فراهم می نماید.
همچنین قفل دار بودن کشوها و محفظه های ترولی بیمارستانی، امکان استفاده غیرمجاز از محتویات داخل ترولی را حذف نموده و به حفظ و نگهداری بهتر آنها کمک می نماید.
استفاده از سیستم کدبندی رنگی
 با توجه به اینکه، بخش های مختلف یک بیمارستان از لحاظ میزان آلودگی موجود و همچنین سطح بهداشت استاندارد مورد نیاز متفاوت میباشند، به منظور جلوگیری از انتقال آلودگی از یک بخش به بخش دیگر و همچنین تامین سطح بهداشت مورد نیاز، هنگام نظافت و شستشوی هر بخش باید از پدهای تی، دستمال های نظافت و حتی مواد شوینده متفاوت استفاده نمود. استفاده از سیستم کدبندی رنگی در چنین مواردی بسیار کارآمد و موثر خواهد بود. در این سیستم برای تفکیک ابزار نظافت و مواد از سطل هایی با دسته های رنگی متفاوت استفاده می شود. همچنین برای تفکیک زباله ها می توان از کیسه های زباله با رنگ های متفاوت استفاده نمود. استفاده از این سیستم در ترولی بیمارستانی، احتمال اشتباه کاربر در استفاده از پد یا مواد نادرست را به حداقل می رساند.
با توجه به اینکه، بخش های مختلف یک بیمارستان از لحاظ میزان آلودگی موجود و همچنین سطح بهداشت استاندارد مورد نیاز متفاوت میباشند، به منظور جلوگیری از انتقال آلودگی از یک بخش به بخش دیگر و همچنین تامین سطح بهداشت مورد نیاز، هنگام نظافت و شستشوی هر بخش باید از پدهای تی، دستمال های نظافت و حتی مواد شوینده متفاوت استفاده نمود. استفاده از سیستم کدبندی رنگی در چنین مواردی بسیار کارآمد و موثر خواهد بود. در این سیستم برای تفکیک ابزار نظافت و مواد از سطل هایی با دسته های رنگی متفاوت استفاده می شود. همچنین برای تفکیک زباله ها می توان از کیسه های زباله با رنگ های متفاوت استفاده نمود. استفاده از این سیستم در ترولی بیمارستانی، احتمال اشتباه کاربر در استفاده از پد یا مواد نادرست را به حداقل می رساند.
استفاده از چرخ های بی صدا و آرام بند برای درپوش ها
 اهمیت حفظ آرامش بیماران، کارکنان و مراجعه کنندگان در محیط بیمارستان ، درمانگاه و یا سرای سالمندان بر هیچکس پوشیده نمی باشد. وجود هر گونه صدای ناخوشایند و آزار دهنده موجب ناراحتی و آزار افراد حاضر در این محیط ها خواهد شد. بنابراین در تولید انواع ترولی ها از چرخ های لاستیکی و نرم استفاده می شود تا هنگام حرکت و جابجایی صدایی ایجاد نکنند. همچنین درپوش های بکار رفته در تولید ترولی بیمارستانی مجهز به پیستون های ضربه گیر و آرام بند می باشند تا باز و بسته کردن درپوش ها، کاملا بی صدا صورت گیرد.
اهمیت حفظ آرامش بیماران، کارکنان و مراجعه کنندگان در محیط بیمارستان ، درمانگاه و یا سرای سالمندان بر هیچکس پوشیده نمی باشد. وجود هر گونه صدای ناخوشایند و آزار دهنده موجب ناراحتی و آزار افراد حاضر در این محیط ها خواهد شد. بنابراین در تولید انواع ترولی ها از چرخ های لاستیکی و نرم استفاده می شود تا هنگام حرکت و جابجایی صدایی ایجاد نکنند. همچنین درپوش های بکار رفته در تولید ترولی بیمارستانی مجهز به پیستون های ضربه گیر و آرام بند می باشند تا باز و بسته کردن درپوش ها، کاملا بی صدا صورت گیرد.
لینک های مفید :
ترولی نظافت : فهرستی از محصولات













